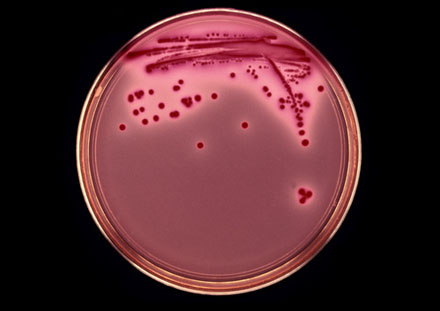

早在2003年,科学家在2400多米的深海中发现了一种奇特的微生物,它们长期生存在含铁、硫等矿物的深海热溢口附近,在121℃高温时仍具有繁殖能力。这株名为“菌株121”的古菌,也是当时已知最为耐热的生命。
如今,微生物承受的温度极限将进一步刷新。科学家发现,同样来自深海热溢区的另一株极端嗜热甲烷古菌“菌株116”,在20MPa高压条件下,其生长的温度极限可由原来的116℃提升至122℃。
恶劣环境为何能成为极端微生物的最佳栖息地?它们到底具有怎样特殊的生命形式?又会对现代生物技术带来何种变革?近日,中国科学院微生物研究所研究员向华分享了这其中的奥秘。
探索生命的极限
在美国黄石国家公园,接近沸点或酸度极强的泉水中仍然有生命顽强存在,大量种类不同的嗜(酸)热微生物聚集在这里,其产生的色素也让泉水呈现出不同色彩,从而形成一道独特的风景线。
近年来,科学家在深海、火山、冰川、盐湖等极端环境中又陆续发现了多种新的生命形式,一些具有独特基因类型的极端微生物在这些“生命禁区”中繁衍生息。
据长期从事极端微生物研究的向华介绍,绝大多数古菌、部分细菌和某些真菌都是极端微生物。按照环境适应性分类,极端微生物主要包括嗜热菌、嗜冷菌、嗜盐菌、嗜酸菌、嗜碱菌、嗜压菌、极端厌氧菌等。有些超级极端微生物还可适应多种极端环境,如嗜酸热、嗜盐碱等。
目前,科学界已发现的支持极端微生物生长的最高温度极限为122℃,pH值最高达11、最低为0,压强达130MPa(相当于13000米水深)以上。而随着研究的不断深入,微生物生存的各种环境极限还将会被不断地刷新。
向华表示,由于细胞的复杂性及其功能的差异,各种生物能承受的温度范围也有所不同。50℃以上,溶氧、水分等就无法满足动植物的生命需求;62℃以上,真核生物细胞器功能会丧失;75℃以上,叶绿素开始降解,通常不再有光合自养菌;100℃以上,细菌的细胞膜结构就会被摧毁。
同样,保持生物活性的温度也一般不能低于-18℃,否则细胞内就会形成冰晶,继而损毁细胞结构,最终导致生物大分子功能的丧失。
奇特的是,在-50℃到150℃这一温度的两极附近,却仍发现有古菌生存的迹象。“因此,生命极限的边界通常由具有特殊细胞结构及代谢能力的极端古菌界定。”向华说。
向华解释称:“嗜热古菌之所以耐高温,原因在于它具有特殊的细胞膜结构、热稳定的蛋白组及受保护的基因组。同时其生活方式多为化能自养,通过摄取无机物等简单物质就可以产生能量。而嗜冷古菌耐低温的原因则是其胞内具有防冻剂功能的相似相容性物质,它可以保护胞内蛋白不受损伤。另外,嗜冷古菌由于蛋白柔韧性较好,因此在极低温度下仍可生活。”
而对于嗜盐古菌,由于其细胞具有泵入钾离子、排出钠离子的选择能力,能以细胞内积累高浓度钾离子来对抗外界高渗环境,同时胞内蛋白已全面适应高钾环境,因此在饱和盐浓度下仍然具备鲜活的生命力。
除此之外,另一种能够在高强度辐射环境下生存的抗辐射球菌也颇具吸引力。“一般人吸收辐射剂量10Gy就会致死,而抗辐射球菌在20kGy,即人致死剂量的2000倍下依然能很好地生存。”
向华表示,抗辐射球菌对电离辐射、紫外线和一些DNA损伤剂都具有极强的抵抗能力,这种超强抗辐射的作用机制也与其DNA损伤的高效修复、对活性氧自由基的有效清除以及特殊的物质结构(如色素等)和生存方式有关。
更有意思的是,一些嗜盐古菌也具有类似的抗辐射能力,显示不同微生物具有适应特定环境的趋同进化。
广泛的应用前景
据了解,数十年前极端微生物还是非常稀缺的研究材料,全球只有少数几个研究小组能够获得此类资源。如今,尽管它们依旧神秘,但很多极端微生物都已成为常规的生物工程的研究材料,其新颖的代谢产物也展现出广阔的应用前景。
极端微生物合成的各种酶类,就是工业应用关注的焦点。
据了解,低温酶由于酶催化反应的最适温度较低,可以在卫生要求较高的食品、药品加工等领域大显身手。而嗜热酶因其具有酶制剂的制备成本低、动力学反应快、能耗低、产物纯度高等优点,也广泛应用于分子生物学研究、环境保护、能源利用等领域。
“目前,已形成产业的主要是高温DNA聚合酶和一些洗涤品用极端酶,全球年产值都在数亿美元。”向华表示,在聚合酶链式反应(PCR)中,由于嗜热菌耐热DNA聚合酶“Taq”的使用,才使PCR的专一性、收得率、灵敏度以及操作简便性和自动化程度都有了明显的提高。而高温酶在生物质处理方面的潜力还须进一步挖掘。
值得一提的是,由多种细菌和某些嗜盐古菌在一定条件下产生的一类胞内聚合物——聚羟基脂肪酸酯(PHA),因其具有生物可降解性及组织相容性等特点,也是目前生物材料开发研究的热点。
PHB和PHBV是PHA最为常见的两种类型,其中,PHBV比PHB具有更好的材料性能。不久前,向华研究组还首次发现CO2直接固定进入PHBV进行贮存的新途径。通过进一步遗传、代谢及发酵工程优化,嗜盐古菌有望成为生产PHBV最为价廉物美的“细胞工厂”。而对极端嗜盐古菌相关特殊途径的深入研究,还有望开发出高附加值的医学生物材料。
除此之外,极端厌氧产甲烷古菌还是地球上唯一可生物合成甲烷的生命形式,广泛分布于各种厌氧环境中,其在沼气发酵、有机废物、废水厌氧降解产甲烷过程中都起到关键作用。
同样,其他一些极端微生物也具有巨大的应用潜力。例如,利用嗜酸耐热菌进行生物冶金,可将贫矿和尾矿中金属溶出并回收;嗜盐碱菌及其功能基因可用于盐碱地的修复;抗辐射微生物用于核污染环境治理等。
产业化之路漫长
在向华看来,极端微生物代表了生命的极限适应能力,这种奇特的生命形式也为科学家在研究生命起源、寻找地外生命等方面带来许多重要启示。而如果极端微生物的生存机制和代谢能力能够成功应用的话,也有望改变整个生物技术领域的面貌。
不过,“虽然极端微生物为生物产业发展提供了很多可能性,但自然界的这些功能,并不意味着就可以直接拿来用。”向华对记者称,虽然我国目前已经掌握了极端微生物的部分机理,但离大规模产业化开发还有较为遥远的距离。
“譬如,对于企业来说,过去的发酵罐主要针对普通菌种,而如果涉足极端微生物,就要面临着改造设备工艺等难题。”在他看来,从基础研究到产业化,这之间还有许多复杂的问题需要解决。
向华觉得,应用基础研究仍然是产业化开发的关键和前提,如果国家对此能有更长远的规划和部署,并加强支持力度,将会有力促进极端微生物科学研究及下游开发的发展进程。







